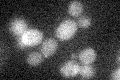
YOL112W
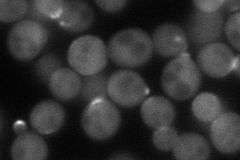
YOL112W
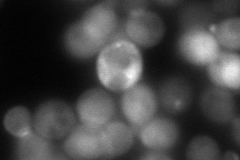
YOL112W

View description
GTPase-activating protein of the Ras superfamily that acts primarily on Sec4p, localizes to the bud site and bud tip, has similarity to Msb3p; msb3 msb4 double mutation causes defects in secretion and actin organization
Localization:
Intensity:
Fold change:
Significance:
-
C’ GFP library in SD
below threshold19.1 -
N' NOP1pr-GFP in SD
bud neck87.5947 -
N' TEF2pr-mCherry in SD
bud neck0 -
N' NATIVEpr-GFP in SD

punctate15.3642 -
N' TEF2pr-VC and Cyto-VN in SD

bud41.1388 -
C’ GFP library in SD+DTT

cytosol24.471.28No -
C’ GFP library in SD+H2O2

cytosol18.030.94No -
C’ GFP library in Starvation Media

cytosol17.370.9No -
C’ GFP library on the background of Pup2-DaMP

below threshold -
C’ GFP library on the background of CCT mutant

below threshold17.66660.924713No
